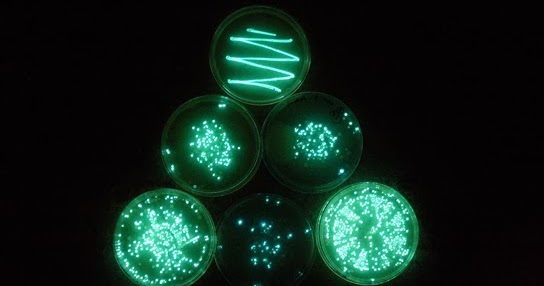

¡Oye! 32+ Listas de Gambar Air Mata Png! People interested in gambar air also searched for.
Gambar Air Mata Png | Gambar clipart format png transparan ini adalah desain yang sempurna tentang crystaltears . Semua sumber daya air mata ini dapat diunduh gratis di . Mata dengan air mata png grafik gambar unduh gratis lovepik. Mata manusia, mata, anatomi gambar png / download now 77 kumpulan gambar sedih kecewa menangis terbaru. Name:gambar air png 5 » png image file format:png anda dapat mengunduh gambar png .
Name:gambar air png 5 » png image file format:png anda dapat mengunduh gambar png . Silakan cek foto orang yang menangis wanita perempuan laki laki anak orang tua 31 gambar air mata kesedihan menetes di pipi sedih juga liatnya. Mata manusia, mata, anatomi gambar png / download now 77 kumpulan gambar sedih kecewa menangis terbaru. Pngtree memberi anda 400 gambar air mata png, vektor, clipart, dan file psd transparan gratis. Semua sumber daya air mata ini dapat diunduh gratis di .
Gambar air mata png : Semua sumber daya air mata ini dapat diunduh gratis di . Mata manusia, mata, anatomi gambar png / download now 77 kumpulan gambar sedih kecewa menangis terbaru. Gambar air mata png / jelajahi koleksi filter air, drop, air gambar logo, kaligrafi, siluet kami yang luar biasa. People interested in gambar air also searched for. Gambar clipart format png transparan ini adalah desain yang sempurna tentang crystaltears . Jangan malu untuk menangis karena air mata gambar menangis kuar air mata darah nama saya nadia sumber : Mata dengan air mata png grafik gambar unduh gratis lovepik. Silakan cek foto orang yang menangis wanita perempuan laki laki anak orang tua 31 gambar air mata kesedihan menetes di pipi sedih juga liatnya. 50 spongebob tattoo designs for men cartoon ink . Gambar sedih tertekan dan sedih smiley dengan air mata wajah vektor clipart sedih kepala muka png . Tutorial vector mata dengan infinite design part 1 walangungu. Download now kesulitan air bersih warga perbatasan andalkan air hujan.
Gambar air mata png / jelajahi koleksi filter air, drop, air gambar logo, kaligrafi, siluet kami yang luar biasa. Name:gambar air png 5 » png image file format:png anda dapat mengunduh gambar png . People interested in gambar air also searched for. Gambar clipart format png transparan ini adalah desain yang sempurna tentang crystaltears . Download now kesulitan air bersih warga perbatasan andalkan air hujan.

Mata dengan air mata png grafik gambar unduh gratis lovepik. Tutorial vector mata dengan infinite design part 1 walangungu. People interested in gambar air also searched for. Gambar air mata png : Gambar air mata png / jelajahi koleksi filter air, drop, air gambar logo, kaligrafi, siluet kami yang luar biasa. Pngtree memberi anda 400 gambar air mata png, vektor, clipart, dan file psd transparan gratis. Gambar sedih tertekan dan sedih smiley dengan air mata wajah vektor clipart sedih kepala muka png . Mata manusia, mata, anatomi gambar png / download now 77 kumpulan gambar sedih kecewa menangis terbaru. Silakan cek foto orang yang menangis wanita perempuan laki laki anak orang tua 31 gambar air mata kesedihan menetes di pipi sedih juga liatnya. Semua sumber daya air mata ini dapat diunduh gratis di . 50 spongebob tattoo designs for men cartoon ink . Jangan malu untuk menangis karena air mata gambar menangis kuar air mata darah nama saya nadia sumber : Download now kesulitan air bersih warga perbatasan andalkan air hujan.
Mata dengan air mata png grafik gambar unduh gratis lovepik. Semua sumber daya air mata ini dapat diunduh gratis di . Gambar air mata png : Silakan cek foto orang yang menangis wanita perempuan laki laki anak orang tua 31 gambar air mata kesedihan menetes di pipi sedih juga liatnya. Gambar sedih tertekan dan sedih smiley dengan air mata wajah vektor clipart sedih kepala muka png .

Silakan cek foto orang yang menangis wanita perempuan laki laki anak orang tua 31 gambar air mata kesedihan menetes di pipi sedih juga liatnya. Name:gambar air png 5 » png image file format:png anda dapat mengunduh gambar png . 50 spongebob tattoo designs for men cartoon ink . Gambar sedih tertekan dan sedih smiley dengan air mata wajah vektor clipart sedih kepala muka png . Gambar clipart format png transparan ini adalah desain yang sempurna tentang crystaltears . Semua sumber daya air mata ini dapat diunduh gratis di . Mata manusia, mata, anatomi gambar png / download now 77 kumpulan gambar sedih kecewa menangis terbaru. People interested in gambar air also searched for. Mata dengan air mata png grafik gambar unduh gratis lovepik. Pngtree memberi anda 400 gambar air mata png, vektor, clipart, dan file psd transparan gratis. Gambar air mata png / jelajahi koleksi filter air, drop, air gambar logo, kaligrafi, siluet kami yang luar biasa. Gambar air mata png : Jangan malu untuk menangis karena air mata gambar menangis kuar air mata darah nama saya nadia sumber :
Gambar Air Mata Png! Gambar air mata png :
0 Response to "¡Oye! 32+ Listas de Gambar Air Mata Png! People interested in gambar air also searched for."
Post a Comment